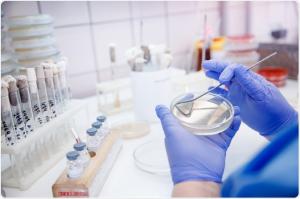
Microbial Identification Market

Microbial Identification Market Top Impacting Factors That Could Escalate Industry's Growth Rapidly
Microbial identification is a technique used to get characterization of the microbes and their relation with environment.
NE WIN SIVERS DRIVE, PROVINCE: - PORTLAND, UNITED STATES, December 17, 2021 /EINPresswire.com/ -- The world microbial identification market is segmented into product, methods, application and geography. Based on the product, the market is segmented into consumables, instruments software and services. The consumable segment consists of plates, reagent & kits, and others. The instrument and software segment is further sub-segmented into bacterial identification system, bacterial resistance identification system, microbial enumeration system, and automatic microbiology analyzers.
๐๐ฒ๐ ๐ฃ๐๐ ๐๐ฟ๐ผ๐ฐ๐ต๐๐ฟ๐ฒ ๐ข๐ณ ๐ง๐ต๐ถ๐ ๐ฅ๐ฒ๐ฝ๐ผ๐ฟ๐ ๐ช๐ถ๐๐ต ๐๐ฒ๐๐ฎ๐ถ๐น๐ฒ๐ฑ ๐๐ป๐ฎ๐น๐๐๐ถ๐ @ https://www.alliedmarketresearch.com/request-sample/856
Microbial identification is a technique used to get characterization of the microbes and their relation with environment. It is of utmost important as microbes can easily contaminate production facilities, products and raw materials. It has outperformed the conventional culture based methods, which are slow and have high risk of error.
This technique is widely used in various stages of drug manufacturing as a part of cGMP, environmental application and in disease diagnostic purpose. Rising food safety concerns, increasing incidences of infectious diseases and technological advancement in products are the major factors driving the growth of the market.
๐๐ผ๐บ๐ฝ๐ฟ๐ฒ๐ต๐ฒ๐ป๐๐ถ๐๐ฒ ๐ฐ๐ผ๐บ๐ฝ๐ฒ๐๐ถ๐๐ถ๐๐ฒ ๐ฎ๐ป๐ฎ๐น๐๐๐ถ๐ ๐ฎ๐ป๐ฑ ๐ฝ๐ฟ๐ผ๐ณ๐ถ๐น๐ฒ๐ ๐ผ๐ณ ๐บ๐ฎ๐ท๐ผ๐ฟ ๐บ๐ฎ๐ฟ๐ธ๐ฒ๐ ๐ฝ๐น๐ฎ๐๐ฒ๐ฟ๐, ๐๐๐ฐ๐ต ๐ฎ๐
Becton Dickinson and Co., bioMerieux SA, Bruker Corp., Charles River Laboratories Inc., Hy laboratories Ltd., Siemens Healthcare, Sigma-Aldrich Corp. and Thermo Fisher Scientific Inc.
๐ ๐(๐ช๐๐๐๐๐๐๐๐ ๐๐๐ ๐ต๐๐ ๐๐๐๐ ๐๐๐๐ ๐ผ๐ ๐๐ 25% ๐ ๐๐๐๐๐๐๐)๐๐
๐ท ๐๐ผ๐๐ถ๐ฑ-๐ญ๐ต ๐ฆ๐ฐ๐ฒ๐ป๐ฎ๐ฟ๐ถ๐ผ:
1) The Covid-19 pandemic and followed by lockdown has affected several manufacturing industries.
2) The prolonged lockdown resulted in a disrupted supply chain and increased the prices of raw materials.
3) However, as the world has been recovering from the pandemic, the market is estimated to get back on track.
๐๐ฒ๐ ๐๐ฒ๐๐ฎ๐ถ๐น๐ฒ๐ฑ ๐๐ผ๐๐ถ๐ฑ-๐ญ๐ต ๐๐บ๐ฝ๐ฎ๐ฐ๐ ๐๐ป๐ฎ๐น๐๐๐ถ๐ ๐ฎ๐: https://www.alliedmarketresearch.com/request-for-customization/856?reqfor=covid
โฏ ๐๐ฒ๐ ๐๐ฒ๐ป๐ฒ๐ณ๐ถ๐๐ ๐ณ๐ผ๐ฟ ๐ฆ๐๐ฎ๐ธ๐ฒ๐ต๐ผ๐น๐ฑ๐ฒ๐ฟ๐
โฆThe study provides an in-depth analysis of the Microbial Identification Market along with the current trends and future estimations to elucidate the imminent investment pockets.
โฆIt offers Microbial Identification Market analysis from 2021 to 2030, which is expected to enable the stakeholders to capitalize on the prevailing opportunities in the market.
โฆA comprehensive analysis of four regions is provided to determine the prevailing opportunities.
โฆThe profiles and growth strategies of the key players are thoroughly analyzed to understand the competitive outlook of the global Microbial Identification Market growth.
๐ง๐ฎ๐ฏ๐น๐ฒ ๐ผ๐ณ ๐๐ผ๐ป๐๐ฒ๐ป๐
CHAPTER 1:INTRODUCTION
1.1.Report description
1.2.Key benefits for stakeholders
1.3.Key Market Segments
1.3.1.List of key players profiled in the report
1.4.Research methodology
1.4.1.Secondary research
1.4.2.Primary research
1.4.3.Analyst tools and models
CHAPTER 2:EXECUTIVE SUMMARY
2.1.Key findings of the study
2.2.CXO perspective
CHAPTER 3:MARKET OVERVIEW
3.1.Market definition and scope
3.2.Key findings
3.2.1.Top investment pockets
3.2.2.Top player positioning
3.3.Market dynamics
3.3.1.Drivers
3.3.2.Restraints
3.3.3.Opportunities...
๐๐ง๐ญ๐๐ซ๐๐ฌ๐ญ๐๐ ๐ข๐ง ๐๐ซ๐จ๐๐ฎ๐ซ๐ข๐ง๐ ๐ญ๐ก๐ข๐ฌ ๐๐๐ฉ๐จ๐ซ๐ญ? ๐๐ข๐ฌ๐ข๐ญ ๐๐๐ซ๐: https://www.alliedmarketresearch.com/purchase-enquiry/856
๐๐๐ฒ๐ป๐๐ฒ ๐๐ฎ๐๐ถ๐ฐ ๐ฃ๐น๐ฎ๐ป | ๐๐ถ๐ฏ๐ฟ๐ฎ๐ฟ๐ ๐๐ฐ๐ฐ๐ฒ๐๐ | ๐ญ ๐ฌ๐ฒ๐ฎ๐ฟ ๐ฆ๐๐ฏ๐๐ฐ๐ฟ๐ถ๐ฝ๐๐ถ๐ผ๐ป |
Sign up for Avenue subscription to access more than 12,000+ company profiles and 2,000+ niche industry market research reports at $699 per month, per seat. For a year, the client needs to purchase minimum 2 seat plan.
Request for 14 days free trial: https://www.alliedmarketresearch.com/avenue/trial/starter
โWe have also published few syndicated market studies in the similar area that might be of your interest. Below are the report title for your reference, considering Impact of Covid-19 Over This Market which will help you to assess aftereffects of pandemic on short-term and long-term growth trends of this market.โ
๐ง๐ฟ๐ฒ๐ป๐ฑ๐ถ๐ป๐ด ๐ฅ๐ฒ๐ฝ๐ผ๐ฟ๐๐ ๐ถ๐ป ๐๐ฒ๐ฎ๐น๐๐ต๐ฐ๐ฎ๐ฟ๐ฒ ๐๐ป๐ฑ๐๐๐๐ฟ๐ ๐ (๐๐ฒ๐ ๐๐ฝ ๐๐ผ ๐ฎ๐ฑ% ๐๐ถ๐๐ฐ๐ผ๐๐ป๐):
Pharmacogenomics Market โ Opportunity & Industry Forecast, 2026
Cell Therapy Market โ Opportunity & Industry Forecast, 2028
๐๐๐จ๐ฎ๐ญ ๐๐ฌ
Allied Market Research (AMR) is a full-service market research and business-consulting wing of Allied Analytics LLP based in Portland, Oregon. Allied Market Research provides global enterprises as well as medium and small businesses with unmatched quality of "Market Research Reports" and "Business Intelligence Solutions." AMR has a targeted view to provide business insights and consulting to assist its clients to make strategic business decisions and achieve sustainable growth in their respective market domain.
Pawan Kumar, the CEO of Allied Market Research, is leading the organization toward providing high-quality data and insights. We are in professional corporate relations with various companies and this helps us in digging out market data that helps us generate accurate research data tables and confirms utmost accuracy in our market forecasting. Each and every data presented in the reports published by us is extracted through primary interviews with top officials from leading companies of domain concerned. Our secondary data procurement methodology includes deep online and offline research and discussion with knowledgeable professionals and analysts in the industry.
David Correa
Allied Analytics LLP
+1 503-894-6022
email us here
Visit us on social media:
Facebook
Twitter
LinkedIn
Legal Disclaimer:
EIN Presswire provides this news content "as is" without warranty of any kind. We do not accept any responsibility or liability for the accuracy, content, images, videos, licenses, completeness, legality, or reliability of the information contained in this article. If you have any complaints or copyright issues related to this article, kindly contact the author above.